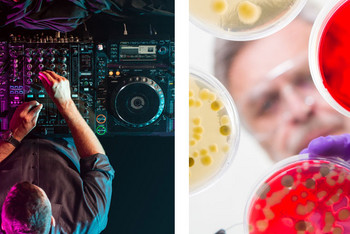

2018
- 2021
Der Sonderforschungsbereich „Re-Figuration von Räumen“ ist der erste soziologie-geleitete Sonderforschungsbereich der DFG. Die Wissenschaftler/-innen haben sich zum Ziel gesetzt, die umfassenden…
2018
- 2020
Im Projekt untersuchten Wissenschaftler/-innen der IRS-Forschungsabteilung „Kommunikations- und Wissensdynamiken im Raum“ und der Adam-Mickiewicz-Universität Poznań sozio-räumliche…
2018
- 2021
Das Forschungsvorhaben „Estates after Transition – Großwohnsiedlungen nach der Transformation“ zielt auf die Untersuchung aktueller Stadtentwicklungsprozesse in postsozialistischen…
2018
- 2021
The DFG- scientific network “The Spaces of Global Production: The Territorial Dimensions of Global Production Networks and World City Networks” connects scholars from Germany, Luxemburg and Belgium…
2016
- 2019
Das Forschungsprojekt ist Teil der interdisziplinären, DFG-Forschergruppe „Organisierte Kreativität: Praktiken der Induktion von und Umgang mit Unsicherheit“. Die empirische Analyse eines…
2016
- 2021
Die Europäische Kommission konstatiert in ihrem Bericht „Social innovation research in the European Union“ (EU 2013) einen Mangel an Forschungen zu sozialen Innovationen in ländlichen Regionen.…
2015
- 2018
Die ‚autogerechte Stadt‘ in der Kritik.
Die Diskussion über den Erhalt, Abriss oder Umbaumaßnahmen des gebauten Erbes der ‚autogerechten Stadt‘ erfährt gerade unter den sich verändernden…
2012
- 2016
Die Dissertation beschäftigte sich mit Nutzer-Innovationen, verstanden als neue Produkte oder Dienstleistungen, die nicht in Organisationen oder Forschungs- und Entwicklungsabteilungen entwickelt…
2014
- 2018
Windenergie wird als eine zentrale Technologie zur Verwirklichung von Klimaschutzzielen und der Förderung ländlicher Regionen gesehen. Viele Länder unterstützen daher den Bau von Windenergieanlagen.…
2017
- 2020
Stadtquartiere sehen sich immer stärker einem Wandlungsdruck ausgesetzt, der durch Entwicklungen von Warenproduktion, -konsumption und -transport erzeugt wird. Die Bestellung und Lieferung von Waren…